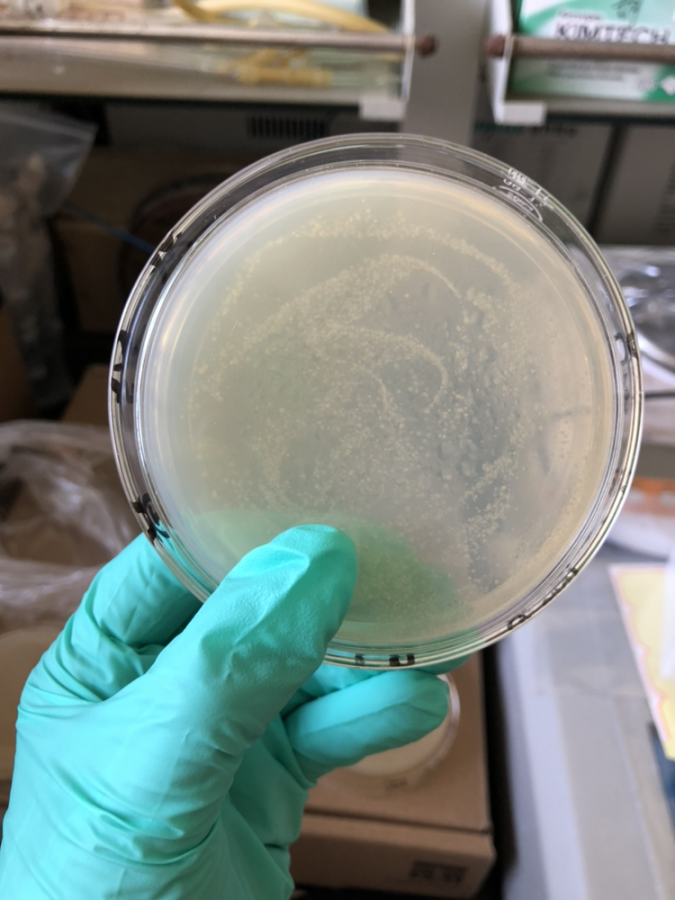
细菌涂布 - 微生物 - 培养/筛选 - 小木虫论坛-学术科研互动平台

涂布棒微生物

微生物检查用品细胞涂布棒(玻璃制)bacteria spreaderコーンラージ棒
图片尺寸500x500
细菌涂布 - 微生物 - 培养/筛选 - 小木虫论坛-学术科研互动平台
图片尺寸675x900
【一次性无菌涂布棒品牌】一次性无菌涂布棒什么牌子好_一次性无菌
图片尺寸360x360
细菌涂布 - 微生物 - 培养/筛选 - 小木虫论坛-学术科研互动平台
图片尺寸675x900
nest耐思 一次性细菌涂布棒微生物平板l型涂布棒 独立包装 711001
图片尺寸800x800
巴罗克biologix651001一次性l型无菌细胞塑料涂布棒涂抹棒
图片尺寸800x800
微生物检查用品细胞涂布棒(不锈钢制)bacteria spreadersusコーンラー
图片尺寸1000x1000
微生物培养用一次性涂布棒
图片尺寸800x800
一次性塑料涂布棒l型,独立包装
图片尺寸3000x2000
巴罗克塑料涂布棒培养皿biologix65-1001一次性l型微生物无菌细胞涂抹
图片尺寸800x800
nest 一次性细菌涂布棒 微生物检测 l型 独立包装 711001 涂布棒 整包
图片尺寸800x800
韩国15包邮微生物实验用耐高温不锈钢涂布棒30mm涂抹棒可重复使用
图片尺寸800x800
玻璃三角涂布器 培养皿涂布器微生物实验推棒可开票l型推刮器包邮
图片尺寸800x800
亚速旺细胞涂布棒(不锈钢制)hkb3(10支/袋)
图片尺寸360x360
微生物培养用一次性涂布棒
图片尺寸800x800
3ul,活化过夜直接于lb 四环素(1000:1)中稀释,然后用涂布棒涂板
图片尺寸640x480
巴罗克细胞推刮器/涂布棒
图片尺寸1920x1650
细胞推刮器无菌l型涂布棒三角形细胞涂布棒一次性平板涂布棒
图片尺寸768x768
细菌涂布棒(玻璃制)
图片尺寸500x500
304不锈钢涂布棒 玻璃涂布棒 实验室细菌涂布棒三角棒 细胞涂布棒
图片尺寸800x800